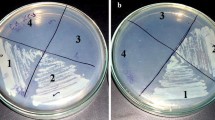

Abstract
Phosphomannose isomerases (PMIs) in bacteria and fungi catalyze the reversible conversion of d-fructose-6-phosphate to d-mannose-6-phosphate during biosynthesis of GDP-mannose, which is the main intermediate in the mannosylation of important cell wall components, glycoproteins, and certain glycolipids. In the present study, the kinetic parameters of PMI from Streptomyces coelicolor were obtained, and its function on antibiotic production and sporulation was studied. manA (SCO3025) encoding PMI in S. coelicolor was deleted by insertional inactivation. Its mutant (S. coelicolor∆manA) was found to exhibit a bld-like phenotype. Additionally, S. coelicolor∆manA failed to produce the antibiotics actinorhodin and red tripyrolle undecylprodigiosin in liquid media. To identify the function of manA, the gene was cloned and expressed in Escherichia coli BL21 (DE3). The purified recombinant ManA exhibited PMI activity (K cat/K m (mM−1 s−1 = 0.41 for d-mannose-6-phosphate), but failed to show GDP-d-mannose pyrophosphorylase [GMP (ManC)] activity. Complementation analysis with manA from S. coelicolor or E. coli resulted in the recovery of bld-like phenotype of S. coelicolor∆manA. SCO3026, another ORF that encodes a protein with sequence similarity towards bifunctional PMI and GMP, was also tested for its ability to function as an alternate ManA. However, the purified protein of SCO3026 failed to exhibit both PMI and GMP activity. The present study shows that enzymes involved in carbohydrate metabolism could control cellular differentiation as well as the production of secondary metabolites.
Similar content being viewed by others
Avoid common mistakes on your manuscript.
Introduction
Phosphomannose isomerases (PMIs) catalyze the reversible conversion of d-fructose-6-phosphate to d-mannose-6-phosphate, which is subsequently acted upon by phosphomannomutase (PMM) and GDP-d-mannose pyrophosphorylase (GMP) to generate mannosylated glycans. These products constitute important cell wall components in bacteria and fungi, nucleotide sugars, glycoproteins, and certain glycolipids (Dunwell et al. 2000; Sousa et al. 2010). PMIs in general are classified into four structurally unrelated distinct classes: type I PMIs that require zinc as a cofactor for their enzymatic activity, type II PMIs that exhibit both PMI and GMP activities, type IV with both PMI and phosphoglucoisomerase activities, and type III with a single protein from Sinorhizobium meliloti (Hansen et al. 2004; Jensen and Reeves 1998). PMIs have been extensively studied in bacteria and are important in controlling a wide variety of functions. Type I PMIs that catalyze a single isomerization reaction have been described in bacteria, fungi, and eukaryotes. The crystal structure of a single type I PMI from Candida albicans providing insights into the active site and metal ion-binding site has also been reported (Cleasby et al. 1996).
Based on functional studies, it has been proposed that type I PMIs essentially control the survival, differentiation, and pathogenesis of an individual organism. A prominent role for type I PMIs in cell growth with mannose as the sole carbon source has been identified in Escherichia coli, Bacillus subtilis, Corynebacterium glutamicum, Saccharomyces cerevisiae, and Aspergillus fumigatus (Elbaz and Ben-Yehuda 2010; Fang et al. 2009; Pitkänen et al. 2004; Sampaio et al. 2003; Sasaki et al. 2011). In B. subtilis, PMI not only controls cellular growth but also cell wall integrity and chromosome morphology (Elbaz and Ben-Yehuda 2010). Similarly, in A. fumigatus, PMI has been shown to be critical for cellular survival, as its deletion leads to defects in cell wall biosynthesis (Fang et al. 2009). Recently, PMI from Photorhabdus luminescens was shown to influence exopolysaccharide production and maintenance, thereby controlling biofilm formation (Amos et al. 2011). Although these studies emphasize the essential roles of PMIs, only limited information is available concerning their effects on the regulation of secondary metabolite production (Lochlainn and Caffrey 2009).
Streptomyces coelicolor is the most well-studied Streptomyces strain and produces two major secondary metabolites, the pigmented antibiotics red tripyrolle undecylprodigiosin (RED) and blue polyketide actinorhodin (ACT) during the transition from vegetative growth to aerial growth (Baltz 1998; Lee et al. 2006). Antibiotic production and sporulation in S. coelicolor are highly affected by the carbon source that includes glucose, xylose, maltose, and N-acetylglucosamine. We previously studied these processes utilizing mannose. We showed that ManB has both PMM and phosphoglucomutase activities, and deletion of manB results in a dramatic increase in ACT production in low-glucose Difco nutrient medium (Yang et al. 2010). As a sequential work, we studied the role of ManA in antibiotic production. We described a novel role for manA, in which it encodes a PMI that affects both sporulation and antibiotic production in S. coelicolor. These results indicate that carbohydrate metabolic pathway enzymes could also be involved in controlling the cellular development and production of secondary metabolites in S. coelicolor.
Materials and methods
Bacterial strains and media
Bacterial strains, primers, and plasmids used in this study are listed in Table 1. S. coelicolor A3(2) M145 was obtained from the Korean Collection for Type Cultures (KCTC, South Korea). E. coli DH5α and E. coli BL21 (DE3) used as host strains for transformation and protein overexpression, respectively, were from the laboratory stock. S. coelicolor A3(2) M145 was grown in R5− medium composed of 103 g of sucrose; 0.25 g of K2SO4; 10.12 g of MgCl2·6H2O; 10 g of glucose; 0.1 g of Difco casamino acids; 2 mL of trace element solution comprised of ZnCl2 40 mg, FeCl3·6H2O 200 mg, CuCl2·2H2O 10 mg, MnCl2·4H2O 10 mg, Na2B4O7·10H2O 10 mg, and (NH4)6Mo7O24·4H2O 10 mg in 1 L of deionized water; 5 g of yeast extract; 5.73 g of TES buffer; and 7 mL of 1 N NaOH in 1 L of distilled water (Kieser et al. 2000). R5−-fructose and R5−-mannose were made by replacing 10 g of glucose with 10 g of fructose and 10 g of mannose. The liquid cultures were grown at 30°C with shaking at 200 rpm in a Hanbaek shaker for 5 days (Hanbaek Scientific Co, South Korea). E. coli strains were routinely cultured in Luria–Bertani (LB) agar and/or liquid broth composed of 3 g of beef extract, 5 g of peptone, and 15 g of agar in 1 L of distilled water. For expression analysis, E. coli cultures were grown at 37°C with shaking at 220 rpm. Antibiotics such as thiostrepton (30 μg/mL) dissolved in DMSO for transformation of S. coelicolor, 50 μg/mL of kanamycin, and 100 μg/mL of ampicillin for transformation of E. coli were added when required to select transformants and maintain plasmids.
DNA manipulations
Cultivation of S. coelicolor strains was performed by following standard procedures (Kieser et al. 2000). Fresh spores of S. coelicolor were collected from R5− agar plates. The entire manA (SCO3025) and SCO3026 were obtained by polymerase chain reaction (PCR) using the primer pair 28manA F–28manA R/28manA2 F–28manA2 R and chromosomal DNA as a template, followed by cloning at the NdeI and HindIII sites of plasmid pET28ma. The resulting recombinant plasmids (p28manA1 and p28-3026) were transformed into E. coli BL21 (DE3). For complementation analysis, manA gene sequences from E. coli and S. coelicolor were amplified using the primer pair SCmanA F–SCmanA R/ECmanA F–ECmanA R, followed by cloning at the EcoRI and HindIII sites of pIBR25 to produce recombinant plasmids p25ECMA and p25SCMA, respectively. The recombinant plasmids were initially transformed into E. coli JM110, re-isolated, and then used to transform S. coelicolor∆manA. SCO3025 encoding ManA was deleted and replaced with an apramycin resistance gene by PCR targeting using oligonucleotide primers with 5′ ends overlapping the upstream (36 bp) and downstream (36 bp) regions of the SCO3025 coding sequence and 3′ (priming) ends designed to amplify the apramycin resistance disruption cassette of pIJ773 and the corresponding cosmid. The mutant was constructed as described previously (Bierman et al. 1992). Plasmid DNA preparation, restriction enzyme digestion, ligation, and transformation of E. coli were performed essentially as reported (Sambrook et al. 1998).
Expression and purification of recombinant ManA and SCO3026
Plasmids p28manA1 or p28-3026 were transformed into E. coli BL21 (DE3), and the resulting transformants were grown at 37 °C with shaking at 220 rpm in 100 mL of LB broth containing 50 mg/L of kanamycin. The cells were grown to an OD of 0.6 at 600 nm, after which 1 mM IPTG was added to the cell broth to induce recombinant protein expression. The cells were harvested after 12 h of induction at 30 °C. For enzyme preparations, the harvested cells were washed and then suspended in 5 mL of 50 mM Tris–HCl buffer (pH 7.5) containing 0.2 mM EDTA, 1 mM phenylmethylsulfonyl fluoride, 0.01% (v/v) 2-mercaptoethanol, and 1 mM 1,4-dithiothreitol. Following this, cells were subjected to ultrasonication for 5 min with ten cycles consisting 15 s each with an interval of 15 s at 4°C (Vibra Cell™ Sonics Scientific, Inc). The supernatant solution containing the soluble proteins was prepared by centrifugation (17,000 × g, 20 min). For purification of His-tagged proteins, soluble proteins were applied to Ni2+-NTA beads pre-equilibrated with base buffer (50 mM NaH2PO4, 0.05% NaCl, 0.05% Tween 20, pH 8.0). Following a 2-h binding reaction, unbound proteins were removed by washing four times with the same buffer containing 20 mM imidazole. Both purified enzymes were eluted three times from the column with 250 mM imidazole buffer, and each purification step was individually analyzed by 12% SDS-PAGE.
Determination of kinetic parameters for ManA
The protein concentration of His-tag-purified ManA was measured with a Bradford assay kit (Bio-Rad Co., USA). PMI activity was determined by following slightly modified previous methods (McCarthy et al. 2005). For PMI activity, 5 μL of purified enzyme (0.37 μg/μL) was mixed with 25 μL of phosphate buffer (0.1 M, pH 7.5), 2 μL of MgCl2 (1 M), 0.5 μL of glucose-6-phosphate dehydrogenase (Roche, Germany), phosphoglucose isomerase (Roche, Germany), 2 μL of NADP+ (50 mM), 55.4 μL of distilled water, and 10 μL of mannose-6-phosphate (100 mM), followed by incubation at 30 °C for 5 min. The rate of change in absorbance was measured in 100 μL of each sample at 340 nm using a 96-well plate and multiscanner (Thermo Electron Corp., Finland). For GMP activity, 50 mM Tris–HCl (pH 7.5), 5 mM Man1-P, 5 mM MnSO4 (MgCl2), 5 mM GTP, and 10 μL of Enz were mixed in a 50-μL reaction at 30 °C for 30 and 60 min. Thin layer chromatography (TLC) was then performed with TLC eluent (isopropanol/25% ammonium hydroxide/water = 10:5:1). The spots were developed using 10% H2SO4 in ethanol and heated.
Complementation of S. coelicolor∆manA
Plasmids p25ECMA and p25SCMA were transformed into S. coelicolor∆manA by a protoplast-mediated method. Briefly, S. coelicolor∆manA was cultured in 25 mL of YEME medium for 48 h at 30°C with shaking at 200 rpm, followed by cell harvesting by centrifugation at 1,000 × g for 10 min. The cell pellet was then resuspended in 15 mL of 10.3% sucrose and centrifuged as above. This washing step was repeated twice. After washing, the mycelium was resuspended in 4 mL of P buffer (Kieser et al. 2000) containing 1 mg/mL of lysozyme. The tubes were incubated at 30°C for 45 min, after which 6 mL of P buffer was added. The prepared protoplasts were filtered using cotton wool, transferred to 15 mL centrifuge tubes, and centrifuged at 3,000 × g for 10 min. Then, the supernatant was discarded and the protoplasts in the pellet fraction resuspended in 50 mL of P buffer. To the prepared protoplasts, 12 μL of individual plasmids was added, followed by immediate addition of 200 μL of T buffer (Kieser et al. 2000) and 500 μL of P buffer. The contents in the tubes were mixed gently, plated on R5− agar medium, and incubated overnight at 30°C. The next day, the plates were overlayed with 1 mL of P buffer containing thiostrepton. Positive transformants were segregated twice and used for further analysis.
Scanning electron microscopy
The spores and hyphae of all the samples were observed by field emission scanning electron microscopy (FE-SEM) (AURIGA, Germany) after 5 days of growth on R5− media. The cut agar blocks were pre-fixed with 2% paraformaldehyde and 2% glutaraldehyde in 0.05 M sodium cacodylate buffer (pH 7.2) and then post-fixed with 1% osmium tetroxide in 0.05 M sodium cacodylate buffer (pH 7.2) for 2 h, followed by dehydration and drying. Each sample was platinum sputter-coated and examined by FE-SEM.
Antibiotic production assays
Antibiotic production was examined in liquid and solid cultures. For the liquid cultures, cells from the R5− solid plates were inoculated and grown for 24 h. Then, they were washed twice with sterilized water and diluted to have the same wet weight in the same amount of water. Exactly 20 mg (wet weight) of cells was inoculated and cultured in a 250-mL baffled flask with 50 mL of R5− without additional carbon sources. The cultures were grown at 30°C with shaking at 200 rpm. One milliliter of each sample was obtained at the specified times. After centrifugation in a micro-centrifuge for 10 min, 900 μL of the supernatant was sampled for further analysis according to previously reported procedures (Bystrykh et al. 1996). ACT and RED were determined spectrophotometrically at 633 and 530 nm, respectively, in the treated samples (150 μL) using a 96-well plate and multiscanner (Thermo Electron Corp., Finland).
Results
Deletion of manA results in bld-like phenotype
The main objective of the present study was to identify the functional role of manA (SCO3025) in S. coelicolor. Initially, the manA gene was inactivated by replacing it with apramycin resistance gene. The manA-deleted strain, S. coelicolor∆manA, exhibited a bld-like phenotype in solid medium (Fig. 1a). When streaked on a R5− plate, S. coelicolor∆manA grew slowly and failed to produce spores. Spores could not be collected by a known spore preparation method (Kieser et al. 2000) and it is different from manB mutant, which showed delayed aerial mycelium formation and sporulation. When glucose was changed to fructose or mannose, the mutant retained its sporulation-defective phenotype, similar to bld mutant (Fig. 1b, c) (Kelemen et al. 2001). Partial spore production with mannose-supplemented complex media (R5−-mannose) was observed; however, the spores were not well defined and displayed a different shape from M145 strain by normal microscopic analysis and SEM, suggesting the sporulation system was still not working properly (Fig. 1c).
Phenotypes of the parent strain of S. coelicolor and its mutant in solid R5− media with different carbon sources such as glucose (a), fructose (b), and mannose (c). Strains were grown on R5− plate with respective carbon sources for 6 days. The parent strain of S. coelicolor sporulated abundantly, and manA-deleted mutant failed to sporulate and exhibited a sporulation-null phenotype
Deletion of manA abolishes antibiotic production in complex media
Based on the sporulation results, the pattern of antibiotic production was also examined. Although S. coelicolor∆manA showed a deficiency in sporulation when cultured on the solid plate, the level of pigment production was higher in comparison to its parent strain. In liquid cultures, S. coelicolor∆manA failed to produce the antibiotics ACT and RED, but successful complementation occurred with manA gene from S. coelicolor (Fig. 2a). For the liquid cultures, cells from the R5− solid plates were inoculated in 3 mL for 24 h and washed twice with sterilized water. Then, the cells were diluted to have the same wet weight and inoculated to 25 mL. The growth of S. coelicolor∆manA was slow, and antibiotic production was abolished in liquid culture (Fig. 2b–d). Interestingly, when S. coelicolor∆manA from the solid plate was inoculated and grown for 3 days without washing, it produced ACT; however, when grown and washed with sterilized water after 1 day, it could not produce any antibiotics, suggesting that there were some other metabolites or factors that affected antibiotic production in liquid culture. These results indicate that manA from S. coelicolor encodes a vital enzyme essential to antibiotic production in liquid culture.
Antibiotic production in S. coelicolor and its mutants in liquid media. a The parent strain of S. coelicolor produced both the pigmented antibiotics ACT and RED (i). S. coelicolor∆manA was found to exhibit a null phenotype for antibiotic production in liquid media (ii). However, antibiotic production was recovered upon complementation of S. coelicolor∆manA with manA (iii). b Growth of S. coelicolor parent strain (M145) (filled circle), S. coelicolor∆manA (empty circle), S. coelicolor∆manA/p25ECMA (filled triangle), and S. coelicolor∆manA/p25SCMA (empty triangle) are shown. ACT (c) and RED (d) production in S. coelicolor parent strain (M145) (empty triangle), S. coelicolor∆manA (empty inverted triangle), and S. coelicolor∆manA/p25SCMA (filled inverted triangle) are shown (n = 3; error bars were intentionally removed for better clarity)
SCO3025 encodes PMI (ManA)
To identify the function of manA in S. coelicolor, the entire manA gene was cloned and overexpressed in E. coli BL21 (DE3). Recombinant ManA was purified to homogeneity (Fig. 3a) and assayed for PMI and GMP activities. ManA exhibited PMI activity with a substrate specificity of K m 0.90 mM towards d-mannose-6-phosphate. The obtained K cat/K m value for ManA was 0.41 mM−1 s−1. A comparison between reported K m values for different organisms and the K cat/K m value of E. coli (70 mM−1 s−1) indicated that this enzyme had low enzymatic activity (Table 2). ManA protein could use Mg2+ ions for its activity despite the presence of a conserved Zn-binding motif as reported previously (Jensen and Reeves 1998). The order of metal ion requirement for ManA was Mg2+ > Cu2+ > Zn2+ due to which the activity levels were 100%, 90%, and 70%, respectively. However, the protein failed to exhibit GMP activity when tested by TLC analysis (data not shown). SCO3026, another ORF in S. coelicolor, was found to have sequence similarity with proteins that could have both PMI and GMP activities (Supplementary material S1). Thus, this protein was also cloned, overexpressed in E. coli BL21 (DE3), and analyzed for PMI and GMP activities. The purified recombinant protein of SCO3026 (Fig. 3b) failed to exhibit both PMI and GMP activities.
Complementation of S. coelicolor∆manA
To confirm that ManA truly influences sporulation, complementation analyses were performed with manA from E. coli and S. coelicolor. S. coelicolor∆manA/pECMA and S. coelicolor∆manA/pSCMA both retained the ability to produce visible spores in solid medium (Fig. 4). Scanning electron microscopic analysis revealed that manA from S. coelicolor was able to recover from the bld-like phenotype only to a certain extent, as viable spores and defective hyphae were observed with similar frequency (Fig. 5). Complementation of S. coelicolor∆manA with manA from E. coli resulted in higher recovery from the bld-like phenotype (Fig. 5). The observed difference in complementation analysis could be attributed to differences in the activities of the individual enzymes based on their kinetic parameters. However, in S. coelicolor∆manA/pSCMA, the recovery of antibiotic production was comparable to that of the parent strain (Fig. 2c, d).
Phenotypes of S. coelicolor and various complemented mutants in solid media. Strains were grown on R5− plate with mannose as carbon source for 6 days. Sporulative phenotype at day 4 (I) and day 6 (II) of parent S. coelicolor (A), bld-like phenotype of manA-deleted mutant (B), and recovery from sporulation-defective phenotype by complementation with S. coelicolor∆manA/p25SCMA (C) and S. coelicolor∆manA/p25ECMA (D) are shown
Phenotypes of S. coelicolor and various complemented mutants as observed by FE-SEM. Samples were prepared with strains shown in Fig. 4 on the sixth day. Distinct sporulation was observed with the parent strain (S. coelicolor M145), whereas manA mutant failed to produce viable spores (S. coelicolor∆manA). Partial recovery from sporulative phenotype was observed with manA from S. coelicolor (S. coelicolor∆manA/p25SCMA), and 100% recovery of sporulative phenotype similar to parent strain was observed with manA from E. coli (S. coelicolor∆manA/p25ECMA)
Discussion
ManA, which catalyzes the isomerization of fructose-6-phosphate to mannose-6-phosphate, is a vital enzyme in the biosynthesis of nucleotide sugars, including GDP-fructose and UDP-GlcNAc (van Heijenoort 2007; Wu et al. 2002). Both of these sugars are involved in peptidoglycan and teichoic acid biosynthesis. In most cases, a defect in ManA production leads to defects in cell wall arrangement. For instance, capsular biosynthesis in Helicobacter pylori, cell wall synthesis and morphogenesis in A. fumigatus, and cell wall integrity in B. subtilis have all been shown to be aberrant when manA expression is altered (Elbaz and Ben-Yehuda 2010; Fang et al. 2009; Wu et al. 2002). Although PMIs have been extensively studied as potential targets for inhibiting the pathogenesis of certain pathogens and have even been used as selectable markers in eukaryotic expression vectors (Degenhardt et al. 2006; Garami and Ilg 2001; Lamblin et al. 2007), very little information is available on the role of carbohydrate metabolic pathway enzymes in sporulation or secondary metabolite production in Streptomyces.
To determine the roles these mannose-related enzymes play, we analyzed the function of ManA in S. coelicolor as a continuation of our previous study on ManB. As observed in H. pylori, A. fumigates, or B. subtilis, deletion of manA was affected the morphogenesis of S. coelicolor, and complete loss of sporulation was observed. Our results concerning the effect of manA inactivation in S. coelicolor clearly indicate that this enzyme is vital for the production of antibiotics and cellular differentiation. Even though complementation analysis with ManA from S. coelicolor and E. coli recovered the bld-like phenotype, the extent of recovery varied. Partial recovery from the bld-like phenotype by ManA from S. coelicolor was observed in the complementation analysis. Compared with the substrate specificity of ManA from other organisms, ManA from S. coelicolor displayed low activity. In comparison to E. coli, the kinetic value for ManA was also very low, which could be attributed to the partial recovery from the sporulative phenotype (Roux et al. 2011).
Despite a lack of information regarding the exact target of mannosylation or how ManA affects sporulation and antibiotic production, the finding on ManA itself is quite interesting. In S. coelicolor, certain genes such as ftsZ, ssgA, and ssgB have been shown to have profound effects in determining sporulation (Flärdh et al. 2000; Flärdh and Buttner 2009; Kawamoto et al. 1997; Keijser et al. 2003). Notably, ssgA and ssgB were shown to control not only sporulation but also production of ACT. Several genes involved in the regulation of sporulation in Streptomyces have also been experimentally proven. The majority of other proteins encoded by similar genes function as either regulatory proteins or transcriptional factors (Xu et al. 2010). However, there has been no report of abolished sporulation and antibiotic production upon deletion of a single metabolic enzyme. Our findings suggest that mannose synthesis-related enzymes such as ManA and ManB are closely related to sporulation and antibiotic production through either control of carbon flux or direct regulation of secondary metabolism. In addition, by considering several reports on glycosylation in Streptomyces (Abu-Qarn et al. 2008; Ong et al. 1994; Wehmeier et al. 2009), the role of manA seems to be beyond just one metabolic pathway as there is evidence of several regulatory functions.
References
Abu-Qarn M, Eichler J, Sharon N (2008) Not just for Eukarya anymore: protein glycosylation in Bacteria and Archaea. Curr Opin Struct Biol 18:544–550
Amos MR, Sanchez-Contreras M, Jackson RW, Munoz-Berbel X, Ciche TA, Yang G, Cooper RM, Waterfield NR (2011) Influence of the P. luminescens phosphomannose isomerase gene, manA, on mannose utilization, exopolysaccharide structure, and biofilm formation. Appl Environ Microbiol 77:776–785
Baltz RH (1998) Genetic manipulation of antibiotic producing Streptomyces. Trends Microbiol 6:76–83
Bierman M, Logan R, O’Brien K, Seno ET, Rao RN, Schoner BE (1992) Plasmid cloning vectors for the conjugal transfer of DNA from E. coli to Streptomyces spp. Gene 116:43–49
Bystrykh LV, Fernandez-Moreno MA, Herrema JK, Malpartida F, Hopwood DA, Dijkhuizen L (1996) Production of actinorhodin related “blue pigments” by S. coelicolor A3(2). J Bacteriol 178:2238–2244
Cleasby A, Wonacott A, Skarzynski T, Hubbard RE, Davies GJ, Proudfoot AEI, Bernard AR, Payton MA, Wells TNC (1996) The X-ray crystal structure of phosphomannose isomerase from C. albicans at 1.7 Å resolution. Nat Struct Biol 3:470–479
Coulin F, Magnenat E, Proudfoot AE, Payton MA, Scully P, Wells TN (1993) Identification of Cys-150 in the active site of phosphomannose isomerase from C. albicans. Biochemistry 32:14139–14144
Degenhardt J, Poppe A, Montag J, Szankowski I (2006) The use of the phosphomannose-isomerase/mannose selection system to recover transgenic apple plants. Plant Cell Rep 25:1149–1156
Dunwell JM, Khuri S, Gane PJ (2000) Microbial relatives of the seed storage proteins of higher plants: conservation of structure and diversification of function during evolution of the cupin superfamily. Microbiol Mol Biol Rev 64:153–179
Elbaz M, Ben-Yehuda S (2010) The metabolic enzyme ManA reveals a link between cell wall integrity and chromosome morphology. PLoS Genet 6:e1001119
Fang W, Yu X, Wang B, Zhou H, Ouyang H, Ming J, Jin C (2009) Characterization of the A. fumigatus phosphomannose isomerase Pmi1 and its impact on cell wall synthesis and morphogenesis. Microbiology 155:3281–3293
Flärdh K, Buttner MJ (2009) Streptomyces morphogenetics: dissecting differentiation in a filamentous bacterium. Nat Rev Microbiol 7:36–49
Flärdh K, Leibovitz E, Buttner MJ, Chater KF (2000) Generation of a non-sporulating strain of S. coelicolor A3(2) by the manipulation of a developmentally controlled ftsZ promoter. Mol Microbiol 38:737–749
Garami A, Ilg T (2001) The role of phosphomannose isomerase in Leishmania mexicana glycoconjugate synthesis and virulence. J Biol Chem 276:6566–6575
Hansen T, Wendorff D, Schönheit P (2004) Bifunctional phosphoglucose/phosphomannose isomerases from the archaea Aeropyrum pernix and Thermoplasma acidophilum constitute a novel enzyme family within the phosphoglucose isomerase superfamily. J Biol Chem 279:2262–2272
Jensen SO, Reeves PR (1998) Domain organisation in phosphomannose isomerases (type I and II). Biochim Biophys Acta 1382:5–7
Kawamoto S, Watanabe H, Hesketh A, Ensign JC, Ochi K (1997) Expression analysis of the ssgA gene product, associated with sporulation and cell division in S. griseus. Microbiology 143:1077–1086
Keijser BJF, Noens EEE, Kraal B, Koerten HK, van Wezel GP (2003) The S. coelicolor ssgB gene is required for early stages of sporulation. FEMS Microbiol Lett 225:59–67
Kelemen GH, Viollier PH, Tenor J, Marri L, Buttner MJ, Thompson CJ (2001) A connection between stress and development in the multicellular prokaryote S. coelicolor A3(2). Mol Microbiol 40:804–814
Kieser T, Bibb MJ, Buttner MJ, Chater K, Hopwood DA (2000) Practical Streptomyces genetics. John Innes Centre, Norwich
Lamblin F, Aimé A, Hano C, Roussy I, Domon JM, Van Droogenbroeck B, Lainé E (2007) The use of the phosphomannose isomerase gene as alternative selectable marker for Agrobacterium-mediated transformation of flax (Linum usitatissimum). Plant Cell Rep 26:765–772
Lee KW, Joo HS, Yang YH, Song EJ, Kim BG (2006) Proteomics for Streptomyces: “industrial proteomics” for antibiotics. J Microbiol Biotechnol 16:331–348
Lochlainn LN, Patrick Caffrey P (2009) Phosphomannose isomerase and phosphomannomutase gene disruptions in S. nodosus: impact on amphotericin biosynthesis and implications for glycosylation engineering. Metab Eng 11:40–47
McCarthy TR, Torelles JB, MacFarlane AS, Katawczik M, Kutzbach B, DeJardin LE, Clegg S, Goldberg JB, Schlesinger LS (2005) Overexpression of Mycobacterium tuberculosis manB, a phosphomannomutase that increases phosphatidylinositol mannosidebiosynthesis in Mycobacterium smegmatis and mycobacterial association with human macrophages. Mol Microbiol 58:774–790
Ong E, Kilburn DG, Miller RC Jr, Warren RA (1994) Streptomyces lividans glycosylates the linker region of a beta-1,4-glycanase from Cellulomonas fimi. J Bacteriol 176:999–1008
Papoutsopoulou SV, Kyriakidis DA (1997) Phosphomannose isomerase of Xanthomonas campestris: a zinc activated enzyme. Mol Cell Biochem 177:183–191
Pitkänen JP, Törmä A, Alff S, Huopaniemi L, Mattila P, Renkonen R (2004) Excess mannose limits the growth of phosphomannose isomerase PMI40 deletion strain of S. cerevisiae. J Biol Chem 279:55737–55743
Roux C, Bhatt F, Foret J, de Courcy B, Gresh N, Piquemal JP, Jeffery CJ, Salmon L (2011) The reaction mechanism of type I phosphomannose isomerases: new information from inhibition and polarizable molecular mechanics studies. Proteins 79:203–220
Sambrook J, Fritsch E, Maniatis T (1998) Molecular cloning: a laboratory manual, 2nd edn. Cold Spring Harbor Laboratory, Cold Spring Harbor.
Sampaio M, Santos H, Boos W (2003) Synthesis of GDP-mannose and mannosylglycerate from labeled mannose by genetically engineered E. coli without loss of specific isotopic enrichment. Appl Environ Microbiol 69:233–240
Sasaki M, Teramoto H, Inui M, Yukawa H (2011) Identification of mannose uptake and catabolism genes in C. glutamicum and genetic engineering for simultaneous utilization of mannose and glucose. Appl Microbiol Biotechnol 89:1905–1916
Shinabarger D, Berry A, May TB, Rothmel R, Fialho AM, Chakrabarty AM (1991) Purification and characterization of phosphomannose isomerase-guanosine diphospho-d-mannose pyrophosphorylase: a bifunctional enzyme in the alginate biosynthetic pathway of Pseudomonas aeruginosa. J Biol Chem 266:2080–2088
Sílvia Sousa S, Christian Ramos C, Joana Feliciano J, Jorge Leitão J (2010) Bacterial type II PMIs: exploitable bifunctional enzymes for biotechnological applications and the rational design of antimicrobials. In: Elnashar M (ed) Biopolymers. InTech, Rijeka, pp 285–202
Sousa SA, Moreira LM, Wopperer J, Eberl L, Sá-Correia I, Leitão JH (2007) The Burkholderia cepacia bceA gene encodes a protein with phosphomannose isomerase and GDP-D-mannose pyrophosphorylase activities. Biochem Biophys Res Commun 353:200–206
Sthapit B, Oh TJ, Lamichhane R, Liou K, Lee HC, Kim CG, Sohng JK (2004) Neocarzinostatin naphthoate synthase: an unique iterative type I PKS from neocarzinostatin producer Streptomyces carzinostaticus. FEBS Lett 566:201–206
van Heijenoort J (2007) Lipid intermediates in the biosynthesis of bacterial peptidoglycan. Microbiol Mol Biol Rev 71:620–635
Wehmeier S, Varghese AS, Gurcha SS, Tissot B, Panico M, Hitchen P, Morris HR, Besra GS, Dell A, Smith MC (2009) Glycosylation of the phosphate binding protein, PstS, in S. coelicolor by a pathway that resembles protein O-mannosylation in eukaryotes. Mol Microbiol 71:421–433
Wells TN, Coulin F, Payton MA, Proudfoot AE (1993) Phosphomannose isomerase from S. cerevisiae contains two inhibitory metal ion binding sites. Biochemistry 32:294–1301
Wu B, Zhang Y, Zheng R, Guo C, Wang PG (2002) Bifunctional phosphomannose isomerase/GDP-D-mannose pyrophosphorylase is the point of control for GDP-D-mannose biosynthesis in H. pylori. FEBS Lett 519:87–92
Xu D, Seghezzi N, Esnault C, Virolle MJ (2010) Repression of antibiotic production and sporulation in S. coelicolor by overexpression of a TetR family transcriptional regulator. Appl Environ Microbiol 76:7741–7753
Yang YH, Joo HS, Lee K, Liou KK, Lee HC, Sohng JK, Kim BG (2005) Novel method for detection of butanolides in S. coelicolor culture broth, using a His-tagged receptor (ScbR) and mass spectrometry. Appl Environ Microbiol 71:5050–5055
Yang YH, Song E, Park SH, Kim JN, Lee K, Kim E, Kim YG, Kim BG (2010) Loss of phosphomannomutase activity enhances actinorhodin production in S. coelicolor. Appl Microbiol Biotechnol 86:1485–1492
Acknowledgments
This work was supported by WCU program (R322009000102130), Basic Science Research Program (2010–0009942), and Priority Research Centers Program (2009–0094021) through the National Research Foundation (NRF) grant funded by the Korean Government (MEST). This subject is also partially supported by the Korea Ministry of Environment as a “Converging Technology Project (201-101-007)” and the Converging Research Center Program through the National Research Foundation (NRF 2009-0082832).
Author information
Authors and Affiliations
Corresponding author
Additional information
Thangamani Rajesh and Eunjung Song contributed equally to this work.
Rights and permissions
About this article
Cite this article
Rajesh, T., Song, E., Kim, JN. et al. Inactivation of phosphomannose isomerase gene abolishes sporulation and antibiotic production in Streptomyces coelicolor . Appl Microbiol Biotechnol 93, 1685–1693 (2012). https://doi.org/10.1007/s00253-011-3581-z
Received:
Revised:
Accepted:
Published:
Issue Date:
DOI: https://doi.org/10.1007/s00253-011-3581-z